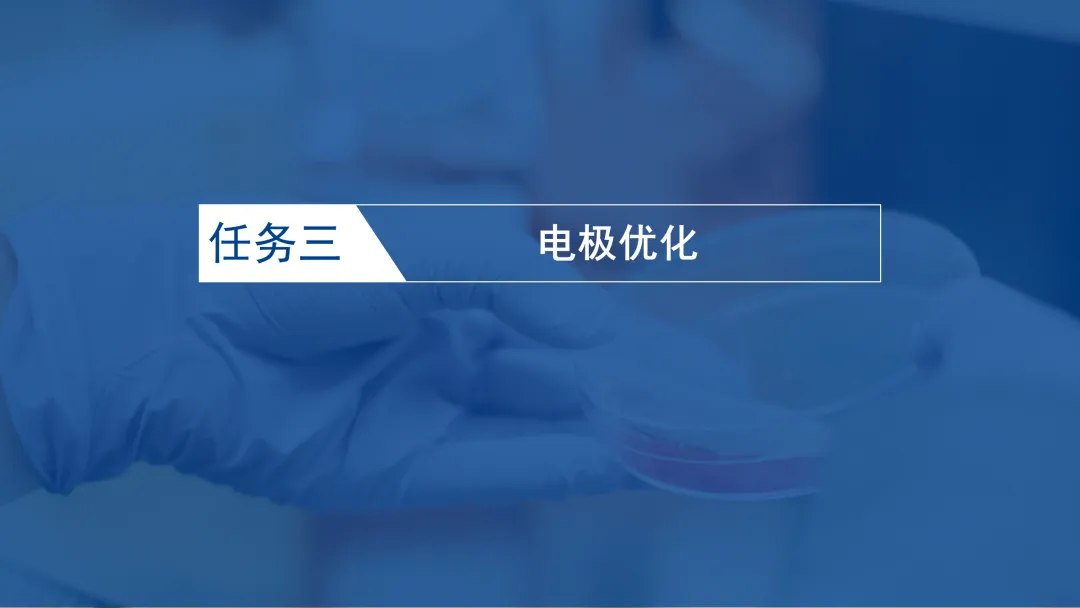

【省级优质课例】电解池的应用(PPT下载)
- 2026-05-21 13:30:08

化学之窗-全国高中化学领军公众号


物质结构与性质疑难解析18讲课件、讲义
研究高考命题方向,精准创作30个重点专题,为2026年高考备考精心打造,针对性极强。配套课件、学案、真题演练,让复习落到实处。赠送的视频,可以反复观看。打造高效复习精品案例,就在高考直通车。

以2025高考为目标,结合近年高考经典试题,按照“知识+题型”的思路,精心设置30个专题。
从考向分析、知识重构、重温经典、模型构建四个模块呈现,全力打造高中化学的知识体系、方法体系、能力体系和素养体系,为提高复习效率提供经典案例!

声明:本文未经授权,禁止转载。

声明:本文未经授权,禁止转载。
本资料下载方法
【第1步】点击下面链接,关注化学之窗;
我用夸克网盘给你分享了「《电解池的应用》.pptx」,点击链接或复制整段内容,打开「夸克APP」即可获取。
链接:https://pan.quark.cn/s/4813c682da4e
欢迎扫码加入化学教学圈子,下载各种教学资源(已发布内容294个,4100多人在用)。

课件下载有效期为一周,过期下载请联系微信44709470.
化学高考直通车精品课程


高中化学高考直通车的课程一般(具体的,请扫码了解详情)包括:
1.讲座视频;2.精品课件PPT(或PPTX格式),均可编辑;
3.讲义(或学案)word版,可编辑;4.练习word版,可编辑。
目前,化学高考直通车有9个系列的课程资源,点击本文末尾左下角的“阅读原文”即可进入平台了解所有课程。



高考一轮复习专用,基于主题教学的2026高考化学专题复习81讲2.0,经典中的经典,全网极具优势的课程资源。化学高考直通车,打造精品教学案例!一直被模仿,从未被超越。



点击上面蓝色文字,即可了解相应课程的配套资源,课件、学案、练习,都是源文件,可以编辑。



来自全国各地的16位名师,针对2024年高考全国甲卷、乙卷、新课标卷、广东卷、河北卷、湖南卷、东三省卷、安徽卷、北京卷、浙江卷、湖北卷、山东卷、广西卷、江西卷等进行深度解析,在此基础上,结合近三年的高考化学试题,对高考命题的规律和解题策略做模型建构,并对教与学提出建议。16讲配套课件、讲义、练习的源文件,课件精美,讲义精致,练习精选,是高三教师必备资料的首选。

 |  |
 |  |

 |  |
 |  |
 |
|

点击上面蓝色文字,即可了解相应课程的配套资源,课件、学案、练习,都是源文件,可以编辑。

化学之窗——高中化学领军公众号
后台回复关键字:
✔回复“hxzc01”:查看必修1、必修2的微课视频;
✔回复“hxzc02”:查看原理、结构、有机的微课视频;
✔回复“hxzc03”:一轮复习、二轮复习的微课视频;
✔回复“hxzc04”:收看精彩科普视频,教学好素材;
✔回复“hxzc05”:高清实验视频+动画模拟1000个;
✔回复“大礼包”:获得化学之窗粉丝特供资料大礼包,大礼包包括:高中化学电子版教材,学案,配套练习,配套课件,配套高清化学实验,一轮、二轮复习课件,配套练习,各种图书Word版,各类优质课、说课的说课稿,视频,历年高考试题等。
大礼包会不定期更新,欢迎大家经常惠顾。
点击文末的“阅读原文”,获得精品课程视频和课程资料。
全国领军微信公众号——化学之窗、化学时代,中学化学师生的朋友!

(分享、点赞、在看)

 点击下面的【阅读原文】,进入化学高考直通车精品资料下载
点击下面的【阅读原文】,进入化学高考直通车精品资料下载

